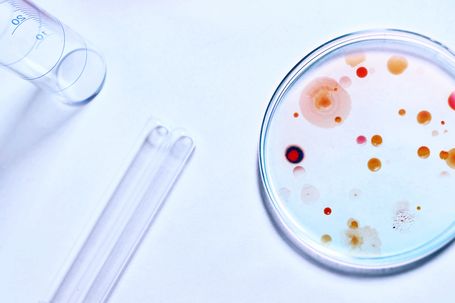

Sustainability meets Performance
ACT is driven by meticulous research and development, adding technical to environmental benefit in many cases.
In other words: we are not simply satisfied with saving CO2 and enabling you to perform more sustainably. We also strive for improved performance in our circular solutions. And the time to ACT is now.
What is ACT?
ACT or Advanced Circular Technologies sums up everything we do to transform our value chain from linear to circular. Starting with raw materials all the way through manufacturing, the use of our solutions and up to the end-of-life. Which is now bound to become a new beginning.
In terms of our products and services, ACT is an overarching term for all technologies that have been redesigned and are based on renewable materials (or technologies).

Towards a Circular Economy
We are launching ACT right now because FUCHS is planning to enter the future zero emission economy early: we aim to become net zero carbon neutral by 2040. Which means you can continue to rely on us without condition – now and in future.

Since 2021: Small Packs with 30% Recycled Material
As early as 2021, our small packages have contained at least 30% post-consumer recycled (PCR) material. Plus, their improved redesign helped you use every last drop ever since.
But to us, 30% are not enough: We are already working on 50% – and even that goal is just the next of many.

Look out for this Icon
Products that are made with or contain Advanced Circular Technologies are labelled with this icon.